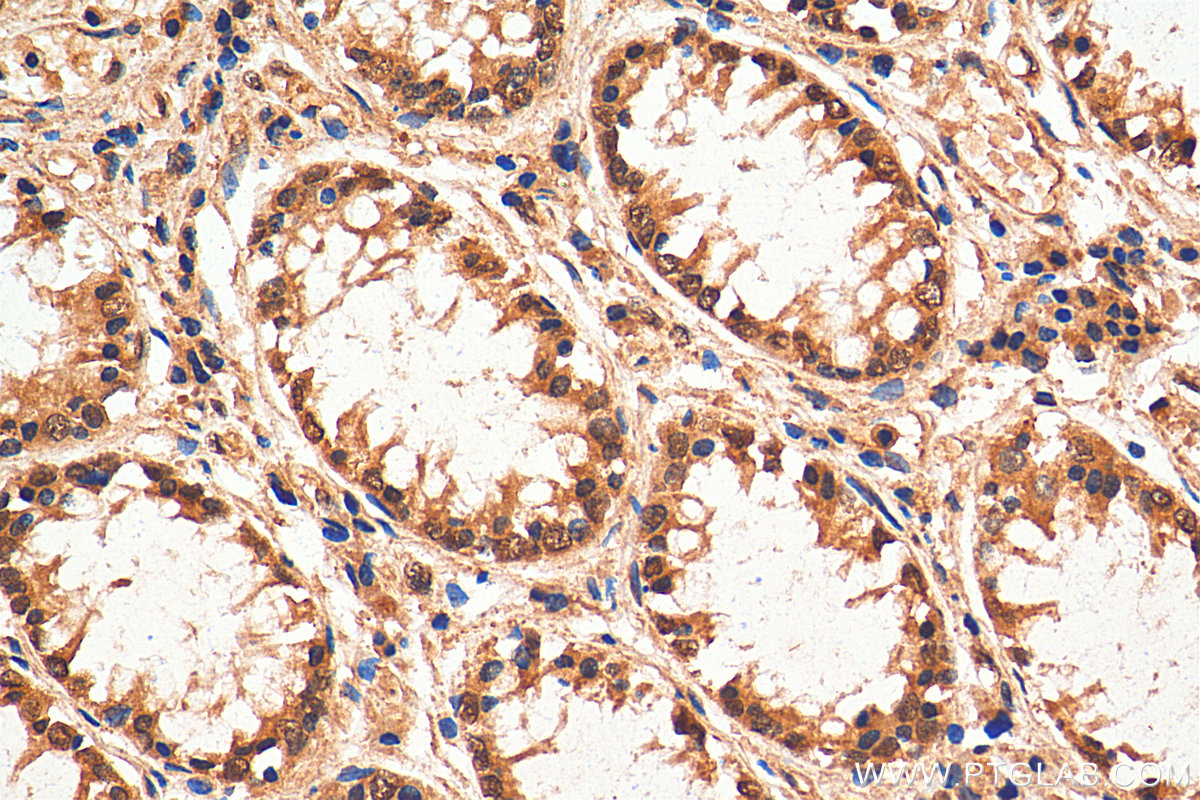

验证数据展示
经过测试的应用
| Positive WB detected in | HEK-293 cells, HeLa cells, MDA-MB-231 cells |
| Positive IP detected in | HeLa cells |
| Positive IHC detected in | human colon cancer tissue, human lung cancer tissue, mouse testis tissue Note: suggested antigen retrieval with TE buffer pH 9.0; (*) Alternatively, antigen retrieval may be performed with citrate buffer pH 6.0 |
| Positive IF/ICC detected in | HepG2 cells, HeLa cells |
推荐稀释比
| 应用 | 推荐稀释比 |
|---|---|
| Western Blot (WB) | WB : 1:1000-1:6000 |
| Immunoprecipitation (IP) | IP : 0.5-4.0 ug for 1.0-3.0 mg of total protein lysate |
| Immunohistochemistry (IHC) | IHC : 1:500-1:2000 |
| Immunofluorescence (IF)/ICC | IF/ICC : 1:200-1:800 |
| It is recommended that this reagent should be titrated in each testing system to obtain optimal results. | |
| Sample-dependent, Check data in validation data gallery. | |
产品信息
13161-1-AP targets SIRT1 in WB, IHC, IF/ICC, IP, CoIP, RIP, ELISA applications and shows reactivity with human samples.
| 经测试应用 | WB, IHC, IF/ICC, IP, ELISA Application Description |
| 文献引用应用 | WB, IHC, IF, IP, CoIP, RIP, ELISA |
| 经测试反应性 | human |
| 文献引用反应性 | human, pig, canine, chicken, zebrafish, sheep, goat, duck |
| 免疫原 |
CatNo: Ag3808 Product name: Recombinant human SIRT1 protein Source: e coli.-derived, PGEX-4T Tag: GST Domain: 1-350 aa of BC012499 Sequence: MIGTDPRTILKDLLPETIPPPELDDMTLWQIVINILSEPPKRKKRKDINTIEDAVKLLQECKKIIVLTGAGVSVSCGIPDFRSRDGIYARLAVDFPDLPDPQAMFDIEYFRKDPRPFFKFAKEIYPGQFQPSLCHKFIALSDKEGKLLRNYTQNIDTLEQVAGIQRIIQCHGSFATASCLICKYKVDCEAVRGALFSQVVPRCPRCPADEPLAIMKPEIVFFGENLPEQFHRAMKYDKDEVDLLIVIGSSLKVRPVALIPSSIPHEVPQILINREPLPHLHFDVELLGDCDVIINELCHRLGGEYAKLCCNPVKLSEITEKPPRTQKELAYLSELPPTPLHVSEDSSSPE 种属同源性预测 |
| 宿主/亚型 | Rabbit / IgG |
| 抗体类别 | Polyclonal |
| 产品类型 | Antibody |
| 全称 | sirtuin (silent mating type information regulation 2 homolog) 1 (S. cerevisiae) |
| 别名 | EC:2.3.1.-, EC:2.3.1.286, hSIR2, hSIRT1, NAD-dependent protein deacetylase sirtuin-1 |
| 计算分子量 | 747 aa, 82 kDa |
| 观测分子量 | 110-130 kDa, 80-85 kDa |
| GenBank蛋白编号 | BC012499 |
| 基因名称 | SIRT1 |
| Gene ID (NCBI) | 23411 |
| RRID | AB_10646436 |
| 偶联类型 | Unconjugated |
| 形式 | Liquid |
| 纯化方式 | Antigen affinity purification |
| UNIPROT ID | Q96EB6 |
| 储存缓冲液 | PBS with 0.02% sodium azide and 50% glycerol, pH 7.3. |
| 储存条件 | Store at -20°C. Stable for one year after shipment. Aliquoting is unnecessary for -20oC storage. |
背景介绍
SIRT1, also named SIR2L1, contains a deacetylase sirtuin-type domain and belongs to the sirtuin family. The post-translation modified SIRT1 is a 110-130 kDa protein, which contains one deacetylase sirtuin-type domain.After phosphorylation modification, this target protein may present double bands ranging from 110 to 120 kDa. The 75-80 kDa SirT1 fragment was detected to lack the carboxy-terminus (PMID:21305533). SirT1 exists a 57-61 kDa isoform. SIRT1 may be found in nucleolus, nuclear euchromatin, heterochromatin, and inner membrane. It can shuttle between the nucleus and cytoplasm. SIRT1 regulates processes such as apoptosis and muscle differentiation by deacetylating key proteins. SIRT1 in particular initiates several signaling events relevant to cardioprotection, including activation of endothelial nitric oxide synthase, INS receptor signaling, and autophagy. In addition, SIRT1 activation elicits resistance to oxidative stress via the regulation of transcription factors and co-activators such as FOXO, Hif-2a, and NF-kB. SIRT1 regulates the p53-dependent DNA damage response pathway by binding to and deacetylating p53, specifically at Lysine 382. This antibody is a rabbit polyclonal antibody raised against residues near the N terminus of human SIRT1.
实验方案
| Product Specific Protocols | |
|---|---|
| IF protocol for SIRT1 antibody 13161-1-AP | Download protocol |
| IHC protocol for SIRT1 antibody 13161-1-AP | Download protocol |
| IP protocol for SIRT1 antibody 13161-1-AP | Download protocol |
| WB protocol for SIRT1 antibody 13161-1-AP | Download protocol |
| Standard Protocols | |
|---|---|
| Click here to view our Standard Protocols |
发表文章
| Species | Application | Title |
|---|---|---|
Cell Metab IgG is an aging factor that drives adipose tissue fibrosis and metabolic decline | ||
Cell Metab Elevation of JAML Promotes Diabetic Kidney Disease by Modulating Podocyte Lipid Metabolism.
| ||
Bioact Mater Silicate ions as soluble form of bioactive ceramics alleviate aortic aneurysm and dissection | ||
Nat Commun Phosphoglycerate dehydrogenase activates PKM2 to phosphorylate histone H3T11 and attenuate cellular senescence | ||
J Pineal Res Melatonin enhances mitochondrial biogenesis and protects against rotenone-induced mitochondrial deficiency in early porcine embryos. |